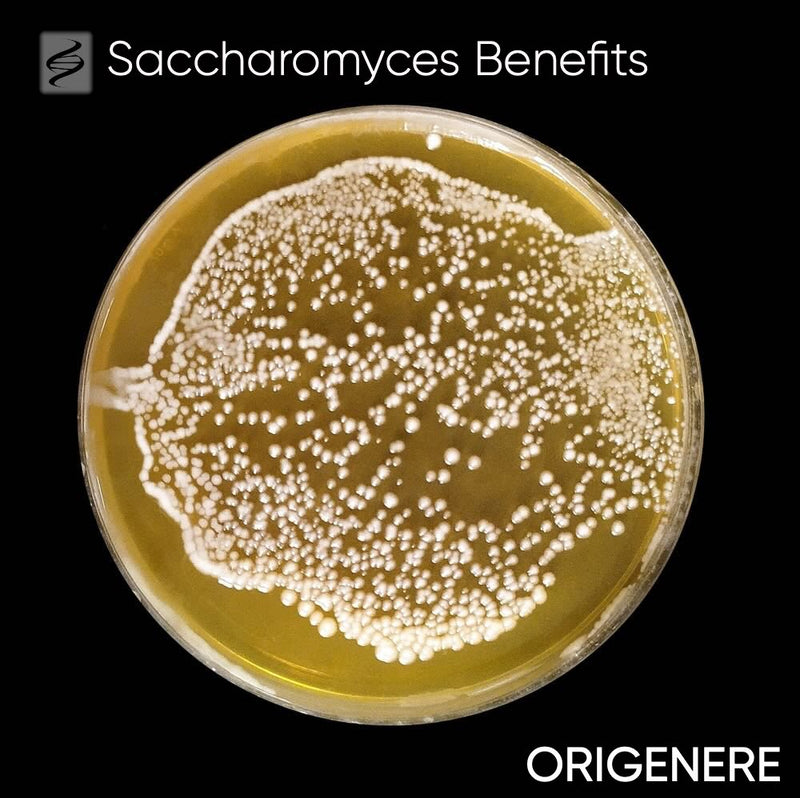
Saccharomyces Ferment Lysate Filtrate

Aloe Vera
Aloe Barbadensis Miller
Aloe vera gel is a scalp-first hydrator rich in polysaccharides (glucomannan), vitamins A/C/E/B12, minerals, and plant sterols. It calms inflammation, supports the skin barrier, balances scalp pH (~4.5–5.5), and helps clear flakes—creating a healthier environment for hair growth. Antioxidant and antimicrobial components further protect follicles and soothe irritation.
Routine support areas
Dandruff
Seborrheic Dermatitis
Irritated Scalp
Dry Scalp
UV/Stress Damaged Skin
Hair Growth
Breakage
Highlight actives
Glucomannan
B-sitosterol
Campesterol
DHT / Hormone-Pathway Considerations
Hormone-pathway consideration
Pregnancy, breastfeeding, and prepubescent use: consult a healthcare provider before use
Safety notes
Topical aloe gel is well tolerated; patch test if sensitive. Avoid contact with the yellow latex layer (can irritate). Oral aloe/latex may cause GI upset and drug interactions; not advised in pregnancy/breastfeeding. Aloe is not a sunscreen despite minor UV-soothing effects.
Found in
Collection
BUONGIORNO VITALITY COLLECTION